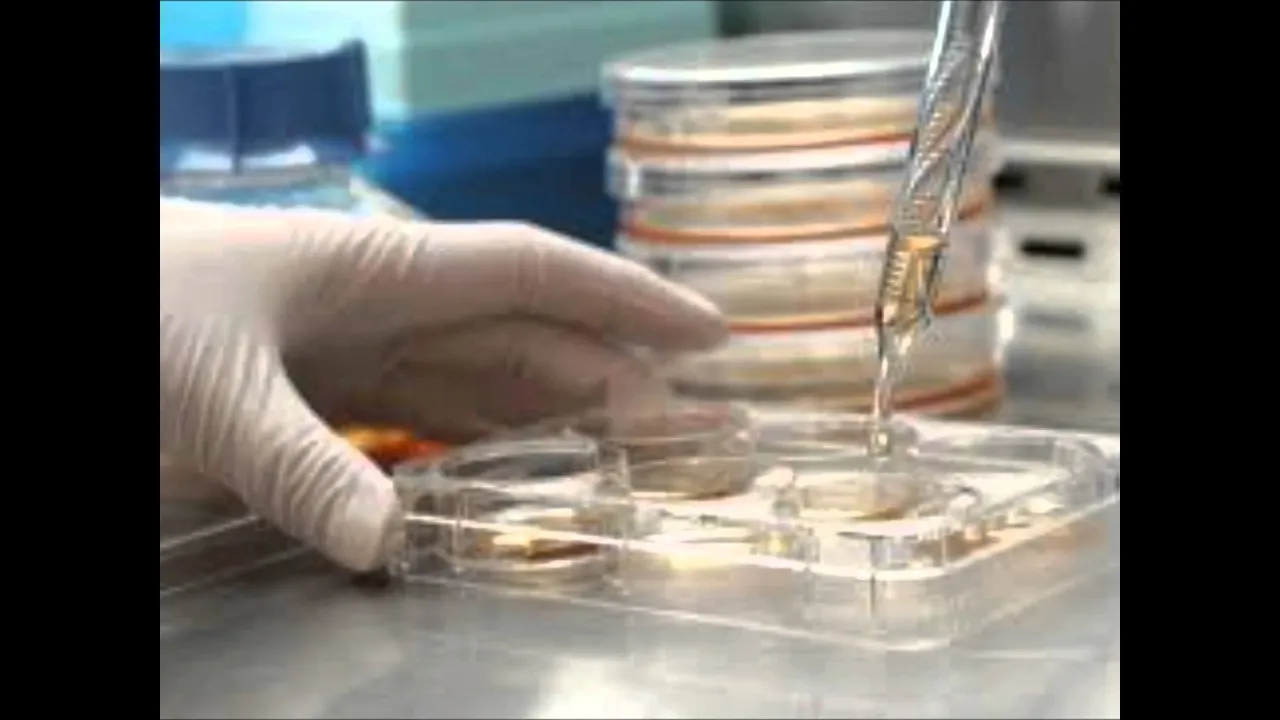

QUE ES EL CONOCIMIENTO CIENTIFICO
Introducción al conocimiento científico
Resumen de la sección: En esta sección, se introduce el concepto de conocimiento científico y su importancia en la comprensión y explicación de la realidad. Se menciona que el conocimiento científico se basa en preguntas que surgen a partir de la observación de la realidad, ya sea en libros o en situaciones cotidianas. Además, se destaca que existen diferentes niveles de ciencia, desde la ciencia básica hasta su aplicación práctica en campos como la medicina. También se menciona el papel de las personas científicamente educadas, como los periodistas científicos, en difundir y compartir el conocimiento científico.
Niveles del conocimiento científico
- El conocimiento científico abarca diferentes niveles: desde la ciencia básica realizada en laboratorios hasta su aplicación práctica.
- Existen preguntas clásicas en la ciencia y también preguntas surgidas por necesidades específicas, como resolver una enfermedad.
- La ciencia tiene un lenguaje complejo que requiere un nivel de comprensión especializado.
- Hay personas encargadas de traducir y aplicar el conocimiento científico en campos como la medicina.
- Surge un grupo de personas no científicas pero apasionadas por la ciencia, como los periodistas científicos.
El método científico
- El método científico es fundamental para obtener conocimientos a través de investigaciones sistemáticas.
- Se basa en la observación empírica y la medición, siguiendo principios específicos de pruebas y razonamiento.
- La hipótesis es una parte importante del método científico, ya que plantea la pregunta a resolver.
- La investigación científica consiste en aplicar el método científico para realizar nuevos descubrimientos y aumentar el conocimiento sobre fenómenos específicos.
- Es necesario medir fenómenos, comparar resultados y interpretarlos teniendo en cuenta variables relevantes.
Importancia de la fuente y actualidad
- Es fundamental conocer la fuente de información científica y asegurarse de que sea actualizada.
- La ciencia avanza rápidamente, por lo que es importante basarse en investigaciones recientes para obtener conclusiones válidas.
Conclusiones
Resumen de la sección: En esta sección final, se destaca la importancia del conocimiento científico como un camino hacia la comprensión de la realidad. Se enfatiza que el método científico es fundamental para realizar investigaciones sistemáticas y obtener nuevos descubrimientos. Además, se resalta la necesidad de contar con fuentes confiables y actualizadas al buscar información científica.
La importancia de la investigación científica
Resumen de la sección: En esta sección, se destaca la importancia de la investigación científica como una forma de llegar a conclusiones basadas en evidencia. Se menciona que la investigación científica utiliza métodos rigurosos y puede involucrar encuestas, entrevistas y análisis de datos. También se enfatiza la necesidad de publicar los resultados en textos científicos para someterlos a debate externo.
- La investigación científica es una forma de llegar a conclusiones basadas en evidencia.
- Utiliza métodos rigurosos que pueden incluir encuestas, entrevistas y análisis de datos.
- Los resultados deben ser publicados en textos científicos para someterlos a debate externo.
El cuidado con las fuentes científicas
- Es importante tener cuidado con las fuentes científicas que empleamos.
- Algunas investigaciones han resultado ser falsas o no estar basadas en la realidad.
- Un ejemplo es el caso de los artículos que relacionaban las vacunas con el autismo, los cuales resultaron ser falsos pero causaron daño a la sociedad.
Rompiendo mitos sobre la ciencia
- Debemos quitar el mito de que solo las personas muy inteligentes pueden ser científicos.
- Hay muchas ramas y formas diferentes de hacer ciencia más allá de la física, química, biología y astronomía.
- Las preguntas científicas pueden ser desde básicas hasta complejas, abarcando diversos temas como el comportamiento humano o fenómenos naturales.
Acercando la ciencia a las escuelas
- Los científicos deberían acercarse a las escuelas para compartir su conocimiento y motivar a los estudiantes.
- La ciencia no solo se trata de libros y estudio teórico, también es una experiencia que se disfruta.
- La ciencia y la tecnología son fundamentales para el progreso de los países y el cambio social sostenido.
Obstáculos en la enseñanza de la ciencia
- Existen diversas razones por las cuales la ciencia no es vista como una meta académica por los estudiantes.
- Algunos maestros pueden transmitir una visión limitada o incorrecta de la ciencia, basándose únicamente en lo que dice un libro sin fomentar el pensamiento crítico.
- Los científicos deberían estar presentes en las aulas para brindar una formación adecuada en metodología científica.
El placer de hacer ciencia
Resumen de la sección: En esta sección, se destaca el disfrute que experimentan los científicos al realizar investigaciones científicas. Se menciona que la ciencia no solo implica trabajo arduo, sino también satisfacción personal. Además, se resalta la importancia de compartir conocimientos con otras personas y promover el debate científico.
- Los científicos disfrutan mucho haciendo ciencia.
- Aunque requiere esfuerzo y dedicación, también brinda satisfacción personal.
- Es importante invitar a las personas a leer y compartir conocimientos científicos, así como participar en debates con otros científicos y el público en general.
Ciencia como camino hacia el progreso
- A nivel mundial, se reconoce que la ciencia y la tecnología son fundamentales para el progreso de los países.
- La ciencia y la tecnología impulsan el cambio social en todos los aspectos de la sociedad.
- Compartir conocimientos científicos a nivel mundial es fundamental para promover el avance y desarrollo de las naciones.
Obstáculos en la percepción de la ciencia
- Existen barreras que dificultan que la ciencia sea percibida como algo accesible y relevante.
- Algunas personas ven a la ciencia como un conjunto de conocimientos difíciles de adquirir, reservados solo para unas pocas mentes privilegiadas.
- Estas percepciones erróneas son impulsadas por factores como una educación deficiente en ciencias y una falta de comprensión sobre cómo se realiza realmente la investigación científica.
El papel de los científicos en las escuelas
- Los científicos deberían estar presentes en las escuelas para compartir su pasión por la ciencia y mostrar a los estudiantes que esta disciplina es accesible para todos.
- Es necesario brindar una formación adecuada a los maestros en metodología científica, para que puedan transmitir correctamente el proceso científico a sus alumnos.
- La ciencia no solo se trata de libros y teorías, sino también de experimentación, descubrimiento y disfrute.
La importancia de estar en todas partes
Resumen de la sección: En esta parte del video, el orador destaca la importancia de estar presentes en diferentes plataformas y lugares para beneficiar a la ciencia y a la sociedad. Menciona que muchas veces los científicos no se quedan en sus países debido a la falta de inversión en ciencia.
La necesidad de invertir en ciencia
- La sociedad no invierte lo suficiente en ciencia, lo cual lleva a que muchos científicos abandonen sus países.
- Aunque México tiene un buen nivel en enseñanza de la ciencia, los científicos mexicanos suelen emigrar debido a la falta de inversión en sus conocimientos.
- Esta realidad se comparte en muchos lugares de América Latina.
El impacto positivo de invertir en ciencia
- Si se enseña cultura científica a la sociedad y esta invierte más en ciencia, es más probable que los científicos se queden en sus países y beneficien directamente a sus naciones.
- Invita tanto a los jóvenes como a los científicos a acercarse a la ciencia y no pensar que es exclusiva para unos pocos. La ciencia tiene un lugar para todos.
El llamado a aprender y quedarse
Resumen de la sección: En esta parte del video, el orador hace un llamado tanto a los estudiantes como a los científicos para acercarse al mundo de la ciencia. Destaca que es posible quedarse en sus países si se adquiere mucho conocimiento, ya que los países industrializados tienen oportunidades para aquellos dedicados a la ciencia.
La importancia de aprender y quedarse
- Es posible quedarse en los países de origen si se adquiere mucho conocimiento en el campo científico.
- Los países industrializados ofrecen oportunidades para aquellos dedicados a la ciencia.
- Invita a aprender y adquirir conocimientos, ya que esto puede abrir puertas en el ámbito científico.
Agradecimiento y cierre
Resumen de la sección: En esta parte final del video, el orador agradece por la solicitud y finaliza su discurso.
Agradecimiento y despedida
- Expresa su gratitud por haber sido solicitado para realizar el video.
- Agradece nuevamente y finaliza su intervención.